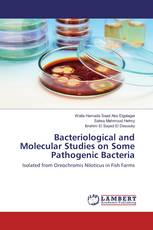

Determination of residual pesticide by using GC, GC-MS and HPLC techniques from fruits and vegetables
Kailas Kapadnis - ISBN: 978-3-659-85294-7
€ 54,90
Vinod Kumar Verma - ISBN: 978-3-659-85143-8
€ 54,90
Ra'ed M. Hassan, Chassib A. Emshary, Shaker I. Easa - ISBN: 978-3-659-83416-5
€ 41,90
Isolated from Oreochromis Niloticus in Fish Farms
Walla Hamada Saad Abo Elgalagel, Salwa Mahmoud Helmy, Ibrahim El Sayed El Desouky - ISBN: 978-3-659-63800-8
€ 39,90

Kseniia Proshina - ISBN: 978-3-659-85273-2
€ 35,90
The rise and fall of the 'Turkish model' in the Muslim world
Muharrem Eksi - ISBN: 978-3-659-85340-1
€ 36,90
Seyed Hossein Mohajeri - ISBN: 978-3-659-82521-7
€ 61,90